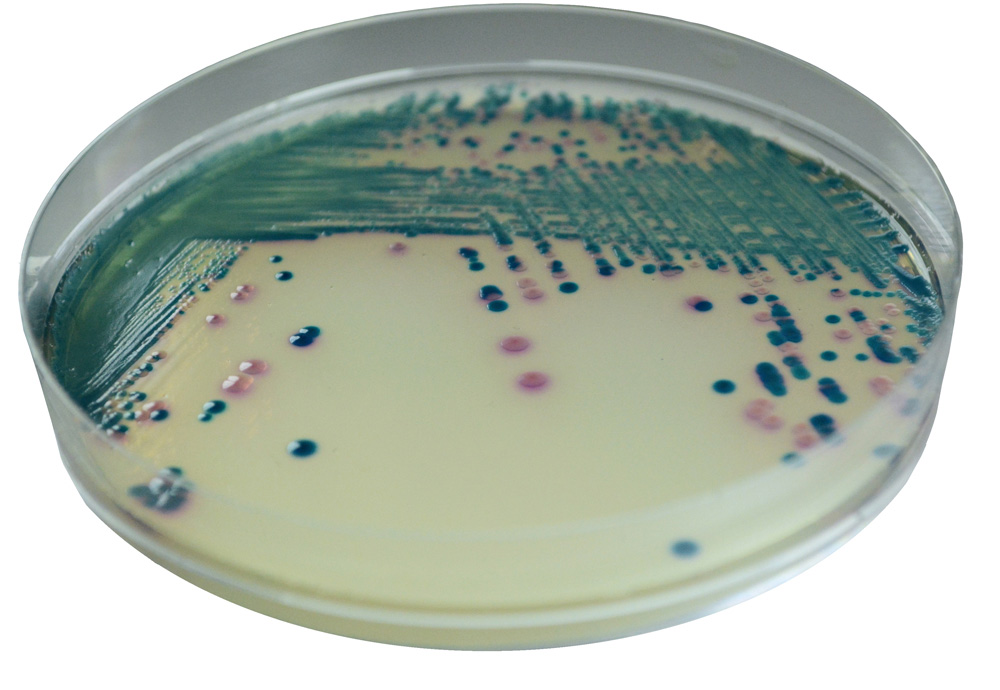

À propos du produit
Milieu chromogène pour la détection et l’isolement des Enterobacteriaceae Productrices de Carbapénèmases (EPC). CHROMAGAR mSuperCARBA détecte un large spectre de carbapénèmases KPC, NDM, IMP, MBL, et OXA incluant OXA-48. La limite de détection minimum est de 10 cfu/mL.